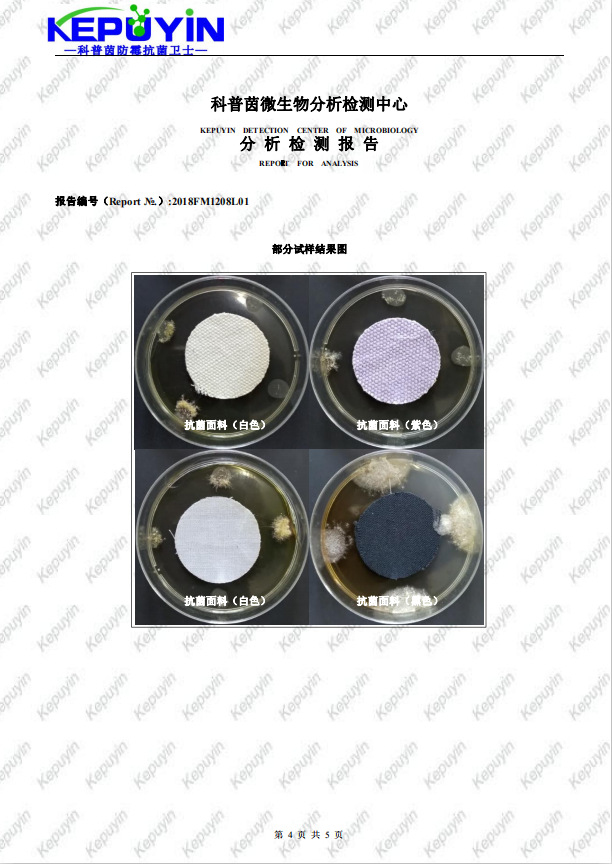
undefined

纺织品防霉抗菌剂 服装防霉剂应用
- 供应商
- 佛山科普茵生物科技有限公司
- 认证
- 品牌
- 科普茵
- 型号
- KEPUYIN-M60
- 产地
- 广东
- 联系电话
- 0757-88788686
- 手机号
- 18620907734
- 经理
- 陈师
- 所在地
- 佛山市南海区大沥镇盐步横江横沙路88号厂房的2楼(住所申报)
- 更新时间
- 2021-10-22 10:56


纺织品防霉抗菌剂KEPUYIN-M60属于广谱型液体防霉剂,采用日化级原料。具有极高的安全性,无毒、无刺激、不燃、无味;对黑曲霉、变色曲霉、绿色木霉、桔青霉、大肠杆菌、金黄色葡萄球菌、白色念珠菌等150种致病菌都有优异的抗菌作用,广谱杀菌。


*抗菌性能优异、杀菌广谱;
*液体配方,易于分散,超高性价比;
*不含DMF、不含甲醛,零VOC,规定使用量下,对人体无毒,满足ROHS、REACH的法规特定要求;
*耐温性良好(100℃以下不分解),耐紫外,耐酸碱可达 pH(4.5-9.5);
*透明,与其它工业原料配伍性好,不改变基体的颜色和其它物理化学性质。


鞋子的面料和里料,袜子毛巾等针织品,贴身内衣裤;床垫、被套、床单等床上用品,毯子、被罩、地毡等室内纺织品等的防霉抗菌处理。

◆浸轧法:
织物经染色或印花后,用浸轧法可将KEPUYIN-M60施于织物上,高温定型烘干。在处理白色的漂白棉布时,应确保在使用KEPUYIN-M60前,把残余的漂白剂全部去除。织物浸轧抗菌溶液(扎余率70%),120~170℃烘干定型。
◆ 用量:KEPUYIN-M60需要用量1%-2.0%(O.W.F)。
加入量可根据产品的性能和使用环境适当调整,在南方高温高湿环境下应用高浓度,在北方和内地可使用低浓度。浅色产品先小样试用,确认对产品颜色无影响再进行大批量生产。

纺织品防霉抗菌剂KEPUYIN-M60主要成分为非氧化性杀菌剂,其穿过细胞膜进入细胞,杂环上的活性部分与细菌体内的蛋白质作用使其键断开。也能与DNA结合,一方面阻断核酸的复制从而抑制微生物的繁殖,另一方面导致基因变异引起蛋白质的合成异常,Zui终导致细胞死亡。辅助成分主要是甾醇脱甲基化抑制剂,通过破坏和阻止病菌细胞膜的重要组成成分麦角甾醇的生物合成导致细胞膜无法形成,致使病菌死亡。经科普茵微生物检测中心检测,纺织品防霉抗菌剂KEPUYIN-M60对黑曲霉、黄曲霉、变色曲霉、桔青霉、宛氏拟青霉、绿色木霉、球毛壳霉、腊叶芽枝霉等8种霉菌和大肠杆菌、金黄色葡萄球菌、桔草芽胞杆菌、巨大芽孢杆菌、荧光假单胞杆菌等5种细菌以及酒精酵母、啤酒酵母等多种酵母菌都显示出良好的抑杀效果。

法规要求
原料在欧盟化学品管理局(ECHA):根据指令98/8/EC(BPD)或规则(EU)No.528/2012(BPR)提交了批准申请的所有活性物质/产品类型组合为PT-2(不直接用于人体或动物的消毒剂和杀藻剂)、PT-6(产品在储存过程中的防腐剂)、PT-7(干膜防霉剂)、PT-9(纤维、皮革、橡胶和聚合材料防腐剂)、PT-10(建筑材料防腐剂)、PT-13(金属工作或切削液防腐剂)。
测试标准
* FZ/T73023-2006抗菌针织品判定方法
* FZ/T60030-2009 家用纺织品防霉性能测试方法
* GB/T24346-2009 纺织品 防霉性能的评价
* GBT20944.3-2008 纺织品 抗菌性能的评价 第3部分:振荡法
* AATCC100-2004 纺织品材料上耐细菌整理:评定

注意事项
佩戴防护衣、橡胶手套和眼罩,避免接触皮肤、眼睛和粘膜。一旦与皮肤和眼睛接触立即用大量清水
及肥皂清洗并及时就医;
可被存储的温度范围为10℃-50℃,任何冻结的产品在解冻之后必须混合充分后使用,不至影响使用效果。装有产品的包装容器不应暴露在阳光下直射。存放在阴凉、干燥、通风良好的地方,不可与不相容物质共同存放。
包装储存
包装及规格:化工塑料桶包装,25kg/桶。






